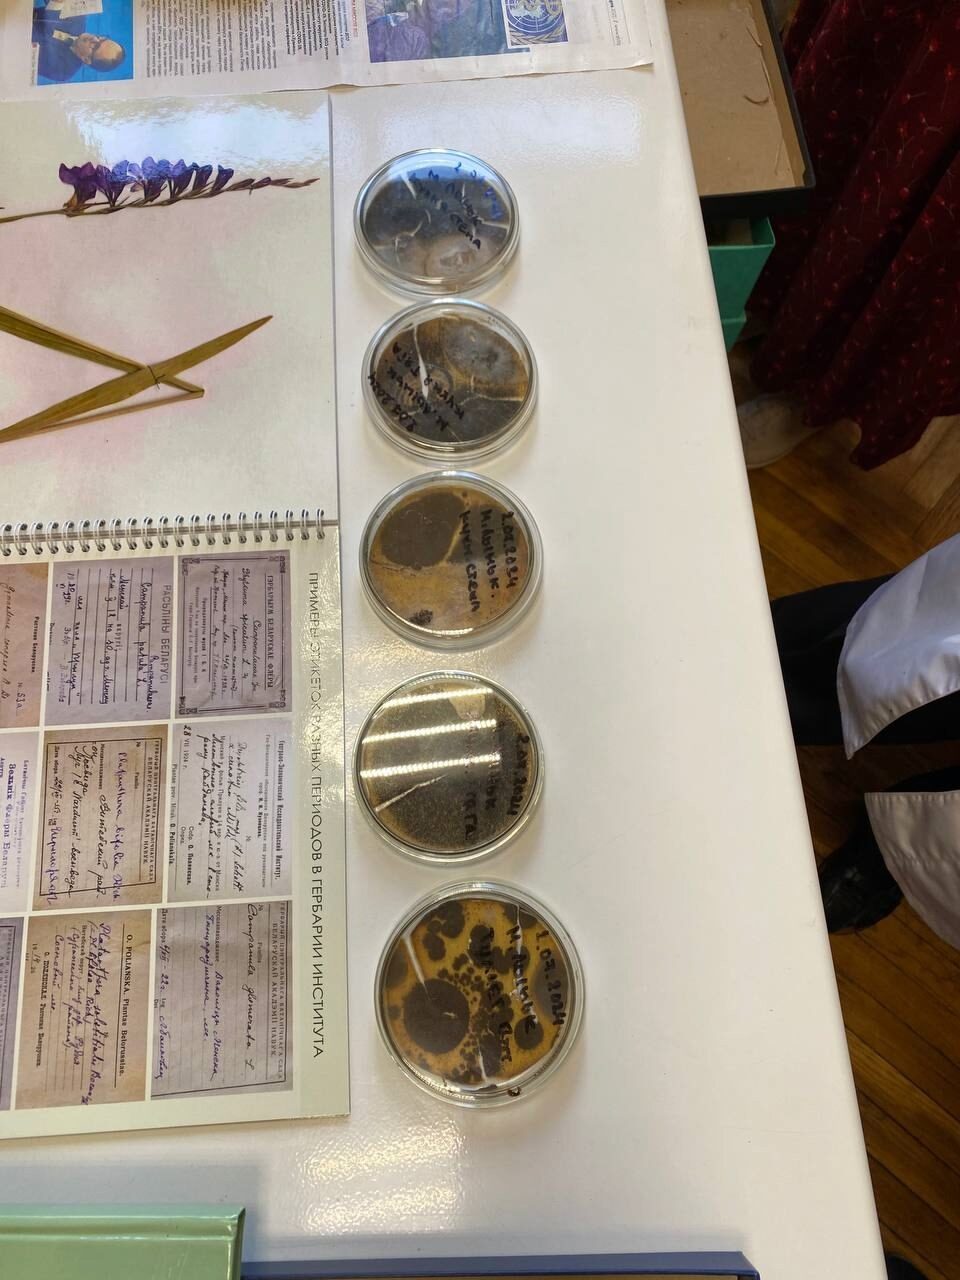

Веб-форма не найдена.
Учёные ЮГУ приняли участия в V Международном научном семинаре «Растительность болот: современные проблемы классификации, картографирования, использования и охраны», который прошёл в Минске в Институте экспериментальной ботаники им. В.Ф.Купревича. В рамках семинара состоялись заседания, на которых были заслушаны и обсуждены доклады о ботанико-географических особенностях болот различных природных регионов и вопросах синтаксономии, разнообразии растительных сообществ, актуальных аспектах геоботанического картографирования, современном состоянии торфяников и динамики восстановления нарушенных болотных экосистем.
Результатами своих исследований поделились инженер-исследователь лаборатории экосистемно-атмосферных связей лесоболотных комплексов Валерия Батршина и лаборант лаборатории геоинформатики экосистем Артём Кулик.
«В своем докладе я сравнила и оценила показатели по шкалам Л. Г. Раменского - увлажнение и активное богатство, а также ботанический состав торфа с территории полевой станции «Мухрино» и территории оз. Пунси, расположенной в Сургутском районе. Результаты показали как схожесть в этапах развития двух территорий, так и различия, выражающиеся в отличительном растительном составе», - рассказала Валерия Батршина.
«Я представлял результат высокочастотных камерных измерений с грядово-мочажинного комплекса болота Мухрино. Как результат, была получена динамика нетто-обмена экосистем и количество поглощенного атмосферного углерода за период исследования - с июня по октябрь 2023 года», - отметил Артём Кулик.
Активное участие в семинаре также приняла директор НОЦ-кафедра ЮНЕСКО «Динамика окружающей среды и глобальные изменения климата» Елена Лапшина. Елена Дмитриевна выступила с докладом «Болотная растительность класса SCHEUCHZERIO-CARICETEA NIGRAE Tx. 1937 в России».
Для участников семинара организовали экскурсию в Березинский биосферный заповедник, учёные также посетили болота Слободское и Домжерицкое. «Особенно впечатлил одновременный рост тростника, папоротника и мха - это было впервые для нас», - поделилась впечатлениями Валерия Батршина.
Кроме того, для участников провели экскурсию по Минску, где гостей города познакомили с главными достопримечательностями Республики. В завершение они самостоятельно посетили Ботанический сад, который поразил своим разнообразием растительности со всего мира.
Результатами своих исследований поделились инженер-исследователь лаборатории экосистемно-атмосферных связей лесоболотных комплексов Валерия Батршина и лаборант лаборатории геоинформатики экосистем Артём Кулик.
«В своем докладе я сравнила и оценила показатели по шкалам Л. Г. Раменского - увлажнение и активное богатство, а также ботанический состав торфа с территории полевой станции «Мухрино» и территории оз. Пунси, расположенной в Сургутском районе. Результаты показали как схожесть в этапах развития двух территорий, так и различия, выражающиеся в отличительном растительном составе», - рассказала Валерия Батршина.
«Я представлял результат высокочастотных камерных измерений с грядово-мочажинного комплекса болота Мухрино. Как результат, была получена динамика нетто-обмена экосистем и количество поглощенного атмосферного углерода за период исследования - с июня по октябрь 2023 года», - отметил Артём Кулик.
Активное участие в семинаре также приняла директор НОЦ-кафедра ЮНЕСКО «Динамика окружающей среды и глобальные изменения климата» Елена Лапшина. Елена Дмитриевна выступила с докладом «Болотная растительность класса SCHEUCHZERIO-CARICETEA NIGRAE Tx. 1937 в России».
Для участников семинара организовали экскурсию в Березинский биосферный заповедник, учёные также посетили болота Слободское и Домжерицкое. «Особенно впечатлил одновременный рост тростника, папоротника и мха - это было впервые для нас», - поделилась впечатлениями Валерия Батршина.
Кроме того, для участников провели экскурсию по Минску, где гостей города познакомили с главными достопримечательностями Республики. В завершение они самостоятельно посетили Ботанический сад, который поразил своим разнообразием растительности со всего мира.
Дата:
11.10.2024